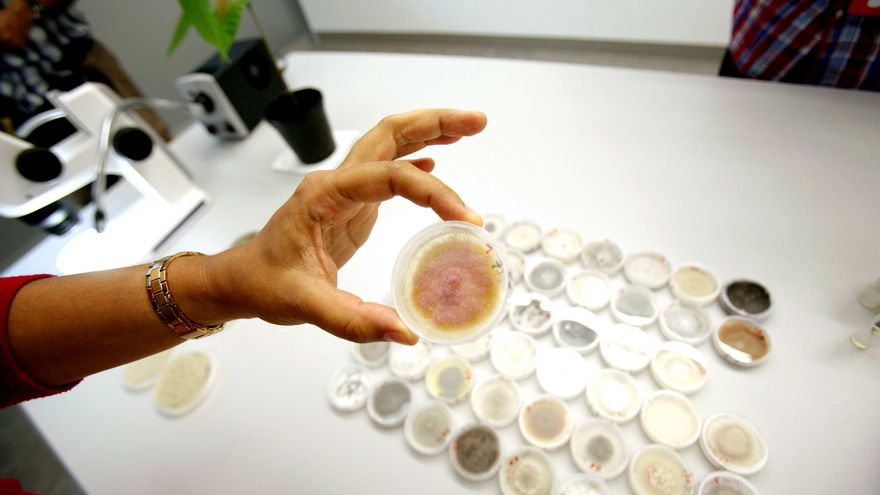

Llamas del Deseo
En vivo
La mutación de un solo gen hace unos dos millones de años desencadenó una serie de cambios en lo que finalmente se convertiría en la especie humana moderna, entre ellos la capacidad para correr, según un estudio publicado hoy en Nature.
Un grupo de investigadores de la Escuela de Medicina de la Universidad de California descubrió que la inactivación de un gen llamado CMAH, que permite la síntesis de un azúcar llamado Neu5Gc, provocó importantes diferencias con la mayoría de primates.
Al tiempo que se produjo esta mutación genética, los antepasados de los humanos comenzaron a andar erguidos y se produjeron cambios muy rápidos en su biomecánica y en la fisiología del esqueleto que dieron como resultado piernas más largas y elásticas, pies más grandes y músculos más potentes.
Estos significativos cambios potenciaron la capacidad humana de correr largas distancias, permitiendo mejorar sus técnicas de caza para alimentarse, según los científicos.
Para llevar a cabo el estudio, el autor principal, el profesor Ajit Varki, y su equipo evaluaron la capacidad para correr de ratones que carecían también del gen CMAH.
Pusieron a los animales a correr en cintas y notaron un aumento en el rendimiento, así como una mayor resistencia a la fatiga y más capilares para aumentar el suministro de sangre y oxígeno.
Así, los datos recabados en el experimento sugirieron que la pérdida del gen CMAH contribuyó a una mejora de la capacidad muscular.
"Si estos hallazgos se trasladan a humanos, es posible que proporcionaran a los primeros homínidos una ventaja selectiva para convertirse en cazadores-recolectores", concluyó Varki.
